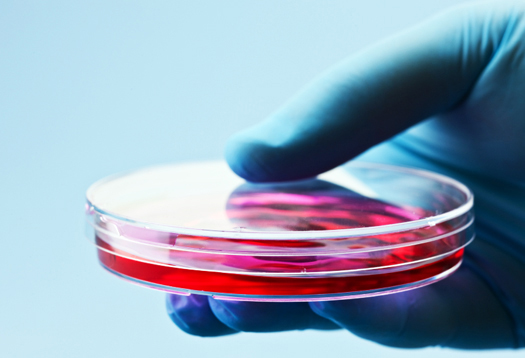

Research
Research is the core of Jenome Technologies.We Innovate,Ideate & create New Research based Product & Services to serve the needs of Industries.Our company includes best Research team to deliver quality product & services.
Our Area of Research:
1.Bioinformatics
2.Genomics
3.Proteomics
4.System Biology
5.Drug Discovery